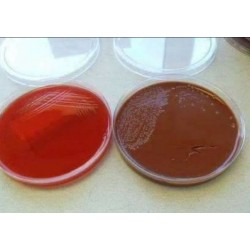
Blood Agar - Chocolate Agar
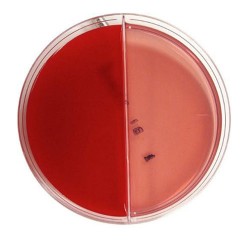
Blood Agar // Blood Agar
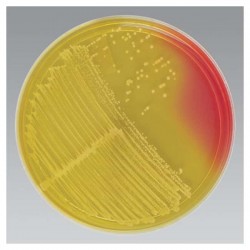
Blood Agar // Mannitol w/Oxacillin

Search Criteria
Products meeting the search criteria
Brand: SISCO
Model: SISCO
Product OverviewAgarose Low EEO for molecular biology9012-36-6
Part B
Storage : Room Temperature
Shelf Life : 60 Months
HSN Code : 13021915
IMDG Identification :Not Regulated for Transport (Non-Haz)Package Size: 100 G..
531.30 SAR
Ex Tax:462.00 SAR
Brand: SISCO
Model: 78711
Product Overview Agarose Low-69012-36-6
Part B
Storage : Room Temperature
Shelf Life : 60 Months
HSN Code : 13021915
IMDG Identification :Not Regulated for Transport (Non-Haz)Package Size: 5 G..
442.75 SAR 442.75 SAR
Ex Tax:385.00 SAR
Brand: abm
Model: Cleaver scientific
Product Overview CleverGEL is a new environmentally friendly agarose suitable for routine analysis of nucleic acids using standard electrophoretic procedures. CleverGEL is manufactured by a process which excludes organic solvents harmful to marine life, making it far kinder to the environme..
342.70 SAR 889.53 SAR
Ex Tax:298.00 SAR..
1,081.00 SAR
Ex Tax:940.00 SAR
Brand: SISCO
Product OverviewB.C.P. - D.C.L.S. Agar
97676(Bromocresol Purple-Deoxycholic Acid-Citrate-Lactose-Sucrose Agar)
Concentration 67.52 gm/lit.Molecular Formula :
Molecular Weight :
Part D
Storage: 8 to 25°C (Cool & dry area)
Shelf Life: 36 Months
HSN Code: 38210000
IMDG Identification: Not Regulat..
290.95 SAR
Ex Tax:253.00 SAR
Brand: SISCO
Model: SISCO
Product Details Baird-Parker Agar, Base (B/S)Concentration 65.00 gm/lit.
Part D
Storage : 8 to 25°C (Cool & dry area)
Shelf Life : 36 Months
HSN Code : 38210000
IMDG Identification :Not Regulated for Transport (Non-Haz)Specifications
Appearance (Colour) Light tan
Appearance (F..
468.34 SAR
Ex Tax:407.25 SAR
Brand: HiMedia
Model: Himedia
recommended for isolation and identification of Yersinia enterocolitica from food and animal feeding stuffs...
2,167.75 SAR
Ex Tax:1,885.00 SAR
Brand: SISCO
Model: SISCO
Product Overview 64104
Bile Salts AgarConcentration 43.00 gm/lit.
Part D
Storage : 8 to 25°C (Cool & dry area)
HSN Code : 38210000
IMDG Identification :Not Regulated for Transport (Non-Haz)Packaging: 500 g..
287.50 SAR
Ex Tax:250.00 SAR
Model: biolab
..
5.00 SAR
Ex Tax:5.00 SAR..
5.00 SAR
Ex Tax:5.00 SAR..
5.00 SAR
Ex Tax:5.00 SAR..
747.50 SAR
Ex Tax:650.00 SAR